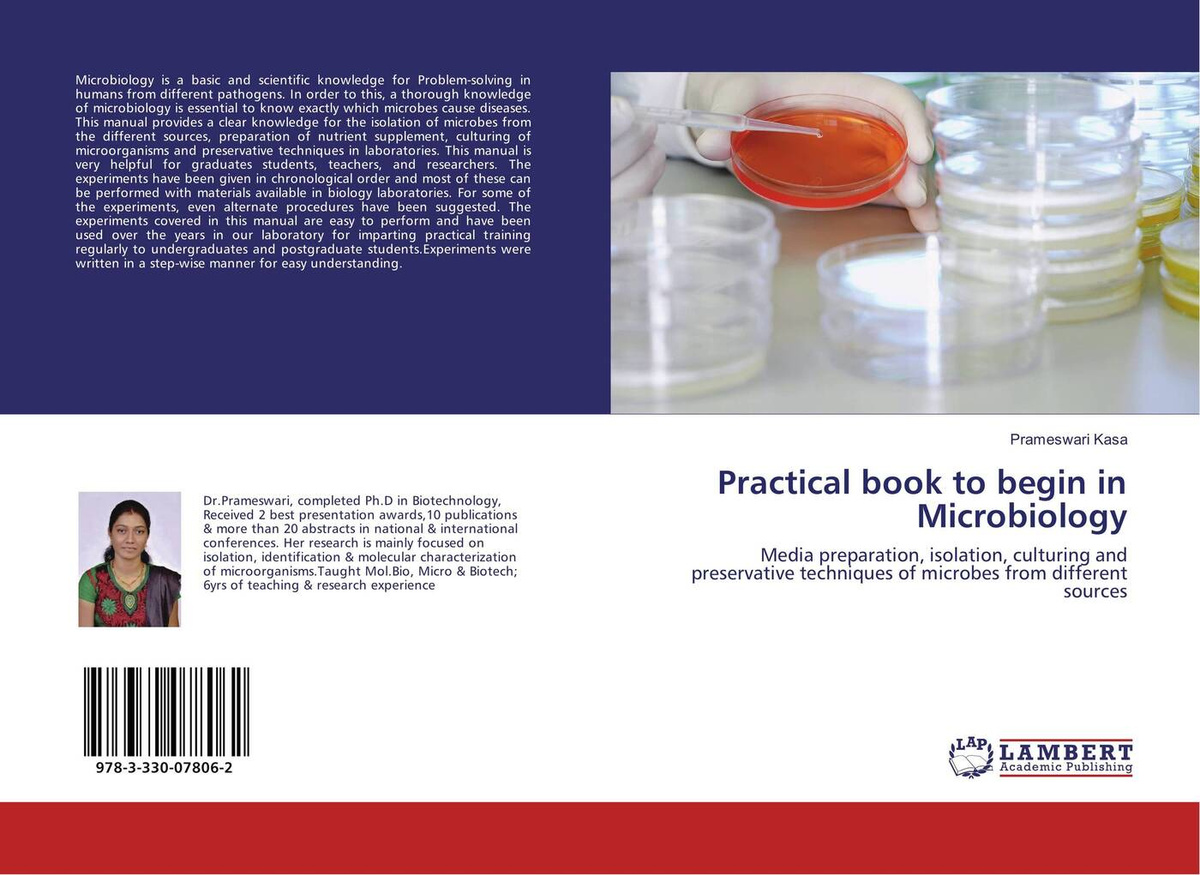

- Формат издания 150x220
- Автор на обложке Prameswari Kasa
- Тип обложки Мягкая обложка
- Количество страниц 92
- Год выпуска 2017
- Тип книги Печать по требованию
- Издатель OmniScriptum Publishing KS
Доступно без регистрации
Преобразование Яндекс Маркет (YML) в Excel
- Преобразовывайте YML-файл в редактируемый документ формата Excel. Конвертируйте из YML в XLSX онлайн
Преобразование Excel (XLSX) в формат Яндекс Маркет
- Преобразовывайте Excel-файл в формат Яндекс Маркет XML (YML). Конвертируйте из XLSX в YML онлайн
Скачивание базы штрихкодов (EAN)
- База содержит информацию о штрихкодах 1 816 200 товаров. Товары встречались в продаже на российском рынке в период с начала 2021 до конца 2022 года
Поиск по библиотеке
- У нас в базе есть информация о 70 миллионах товаров. Проверьте, есть ли там нужные вам товары.
Ключевые свойства товаров
- Результат анализа миллионов вопросов покупателей о том, что им важно. Сгруппированы по типам товаров